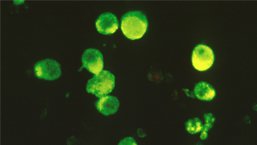
Busulfan Melphalan i Bortezomib w porównaniu do wysokich dawek Melphalanu jako leczenia kondycjonującego przed autologiczną transplantacją macierzystych komórek krwiotwórczych w szpiczaku plazmocytowym

Autotransplantacja macierzystych komórek krwiotwórczych (autoHSCT) jest standardem leczenia szpiczaka plazmocytowego (MM). W młodszej grupie wiekowej tj do 65 roku życia pacjenci odnoszą znaczące korzyściz przeprowadzenia autoHSCT po uzyskaniu remisji choroby. Standardowym leczeniem kondycjonującym przed procedurą jest zastosowanie Melphalanu w dawce 200mg/m2.
Materiał przeznaczony wyłącznie dla pracowników służby zdrowia
Ten materiał jest dostępny dla zarejestrowanych użytkowników.
Zaloguj się
Szanowni użytkownicy,
część materiałów udostępnianych na naszym portalu jest przeznaczona
wyłącznie dla lekarzy.
Wynika to z regulacji prawnych, do których musimy się stosować.
Jeśli nie jesteś lekarzem, zachęcamy do korzystania z przygotowanych przez nas materiałów dostępnych w zakładce dla pacjentów.







